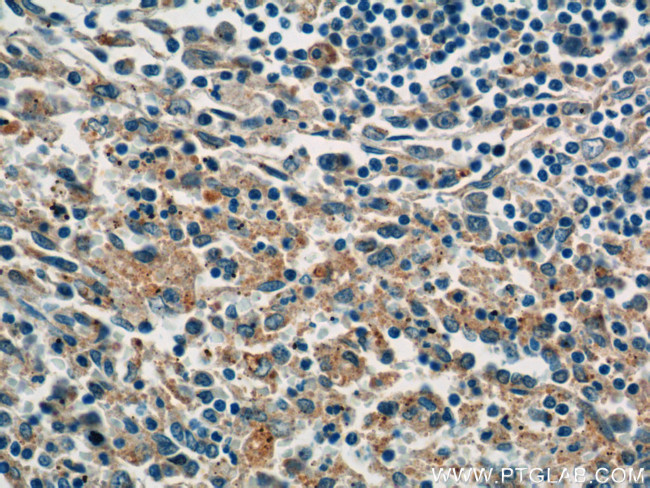
P-selectin Antibody in Immunohistochemistry (Paraffin) (IHC (P))

Search
Proteintech
P-selectin Monoclonal Antibody (3G2C7)
{{$productOrderCtrl.translations['antibody.pdp.commerceCard.promotion.promotions']}}
{{$productOrderCtrl.translations['antibody.pdp.commerceCard.promotion.viewpromo']}}
{{$productOrderCtrl.translations['antibody.pdp.commerceCard.promotion.promocode']}}: {{promo.promoCode}} {{promo.promoTitle}} {{promo.promoDescription}}. {{$productOrderCtrl.translations['antibody.pdp.commerceCard.promotion.learnmore']}}
产品信息
60322-1-IG
种属反应
已发表种属
宿主/亚型
分类
类型
克隆号
抗原
偶联物
形式
浓度
规格
纯化类型
保存液
内含物
保存条件
运输条件
产品详细信息
Immunogen sequence: VCQALQCQD LPVPNEARVN CSHPFGAFRY QSVCSFTCNE GLLLVGASVL QCLATGNWNS VPPECQAIPC TPLLSPQNGT MTCVQPLGSS SYKSTCQFIC DEGYSLSGPE RLDCTRSGRW TDSPPMCEAI KCPELFAPEQ GSLDCSDTRG EFNVGSTCHF SCNNGFKLEG PNNVECTTSG RWSATPPTCK GIASLPTPGV QCPALTTPGQ GTMYCRHHPG TFGFNTTCYF GCNAGFTLIG DSTLSCRPSG QWTAVTPACR AVKCSELHVN KPIAMNCSNL WGNFSYGSIC SFHCLEGQLL NGSAQTACQE NGHWSTTVPT CQDDGKCPLN PHSHLGTYGV FTNAAFDPSP (481-830 aa encoded by BC028067)
靶标信息
P-selectin (Selectin P, GMP-140, LECAM3, CD62 antigen-like family member) is a 140 kDa type 1 transmembrane glycoprotein, and is one of the most commonly studied proteins that regulate cell rolling. P-selectin is stored in the Weibel-Palade bodies of endothelial cells, as well as in a-granules of platelets. From there, it can be rapidly brought to the cell surface after exposure to thrombin, histamine, complement 5a, Ca21 ionophores, or adenosine diphosphate. P-selectin protein redistributes to the plasma membrane during platelet activation and degranulation and mediates the interaction of activated endothelial cells or platelets with leukocytes. P-selectin plays an important role in adhesive processes between leucocytes and endothelial cells, and is a calcium dependent receptor that binds to sialylated forms of Lewis blood group carbohydrate antigens found on neutrophils and monocytes. P-selectin is constitutively expressed in inflammation and contributes to atherogenesis, thrombosis and tissue destruction. Clinically, P-selectin is used to distinguish heparin induced thrombocytopenia with and without thrombosis.
仅用于科研。不用于诊断过程。未经明确授权不得转售。
生物信息学
蛋白别名: CD62 antigen-like family member P; CD62P; FLJ45155; GMP-140; Granule membrane protein 140; granule membrane protein 140kDa; granule membrane protein-140 (GMP-140) precursor; granulocyte membrane protein; LECAM3; Leukocyte-endothelial cell adhesion molecule 3; P-selectin; PADGEM; Platelet activation dependent granule-external membrane protein; platelet alpha-granule membrane protein; RP1-86F14.2; selectin P (granule membrane protein 140kDa antigen CD62) isoform SELP_1; selectin P (granule membrane protein 140kDa antigen CD62) isoform SELP_3; selectin P (granule membrane protein 140kDa, antigen CD62); unnamed protein product
基因别名: CD62; CD62P; GMP140; GMRP; GRMP; LECAM3; PADGEM; PSEL; SELP
UniProt ID: (Human) P16109
Entrez Gene ID: (Human) 6403